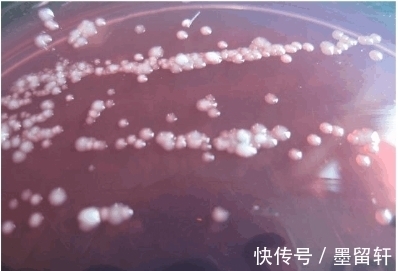
鸡群|养殖户的我们,在伤害鸡肠道的6个原因,值得点击收藏

在鸡养殖中,保持鸡肠道健康,不但能保证鸡的正常生长和较高的的生产性能,而且,能有效防治疾病,减少损失,获得较高的经济效益。鸡肠道健康失衡现象是养鸡生产中较易发生的一种情况,一般表现为鸡只发生下痢、腹泻,粪便稀薄如水状,应该引起人们足够重视。

文章插图
【 鸡群|养殖户的我们,在伤害鸡肠道的6个原因,值得点击收藏】伤害鸡子的原因有哪些?及预防、治疗。
1.霉菌毒素:正所谓霉菌毒素是万病之源,如果鸡群饲喂的饲料霉菌毒素超标,肠道首先受到伤害,然后免疫力大幅下降,各种鸡病也就随之而来了。可在饲料里添加霉立清进行脱霉。
2.球虫病;球虫病是导致鸡肠道疾病发生,影响健康和生产性能的重要疾病之一。可定期给鸡子喂一些白球痢康进行驱虫。
3.饲料问题:有些养鸡户饲喂给鸡群的饲料,不但营养差,而且难以吸收。比如那些粗纤维含量太高,维生素缺乏的饲料,就会破坏肠道内壁。可在饲料中添加复合维生素【速补21】进行补充维生素
4.换料问题:有经验的养鸡户在鸡群换料的时候是不会着急的,比如需要5天完成换料的情况下却3天就换完了,养鸡户是省事儿了,鸡的肠道可受不了啊。
5.饮水问题:鸡群饮用的水如果不卫生,水源不洁净,微生物超标,也会直接伤害肠道,造成拉稀腹泻。防治拉稀可用杆立克进行治疗。
6.环境问题:养鸡的环境不好,各种细菌、病毒和有害微生物在鸡群周边广泛存在,不仅对鸡群肠道是个威胁,对整个养鸡事业都是很大的风险。方案:勤打扫 勤消毒,消毒可使用稀戊二醛和聚维酮碘两种消毒液进行交替消毒。
文章插图
- 食物|胃不好的人,常吃这几种食物,养胃护胃效果好
- 饮食习惯|长寿的人,往往有5个共同点,45岁之后占得越多,健康与你相伴
- 服药|错把抑郁当成叛逆,她差点失去了女儿,抑郁症的人常有4种表现
- 肺栓塞|术后准备出院回家,起来进卫生间再也没出来,危险的卧床值得警惕
- 器官移植|元宵里的“团圆与新生”:上海瑞金医院迎来多名器官移植患者“回家”
- Beth|在吗?!有个急事跟你说!
- 红豆|春天女人打好基础,多吃10种补气血的食物,简单营养,常吃显年轻
- 蚂蟥|这野草名字挺吓人,但根的价值很珍贵,炖肉可治胃痛,你认识吗?
- 导航|黄码了怎么办?用“广州健康通”查最近的可检测机构
- 疾病|酒的味道并不好,爱喝的人却很多,原因是啥?少量饮酒是好是坏?
